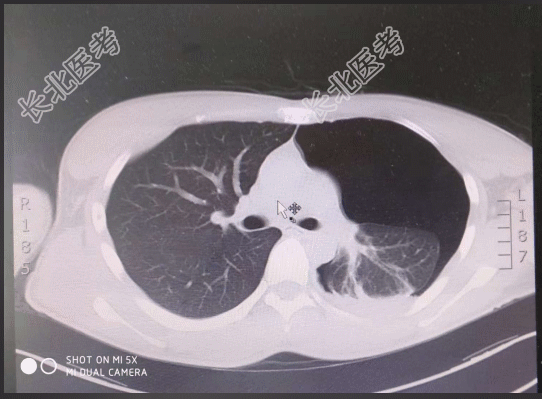

试题详情
- [材料题] 【一般资料】男性,19岁,学生【主诉】剧烈运动后出现左侧胸痛,伴胸闷1天【现病史】患者1天前,跳远后后出现胸痛,呼吸时明显,休息后无缓解,伴有胸闷,无咳嗽、咳痰,无发热,无放射性疼痛,无咯血、晕厥,2018-10-20门诊行肺CT检查阅片提示:左侧气胸,为求进一步诊治,门诊拟“气胸”收入我科,病程中患者神清,精神可,饮食一般,睡眠一般,大小便正常,体重未测。【既往史】一般健康状况良好;否认高血压病史。否认糖尿病病史。否认冠心病病史。否认慢性支气管炎病史。否认胆结石病史。否认胆囊炎病史。否认“肝炎、伤寒”等传染病病史。未发现药物、食物过敏史。无手术史。否认输血史。【查体】T:36.3℃,P:75次/分,R:20次/分,BP:118/75/mmHg。神清,精神可,步入病房,自动体位,言语清晰,查体合作。皮肤黏膜:无黄染皮疹,无瘀点、瘀斑,无紫绀水肿。浅表淋巴结未触及肿大。头部无畸形,双瞳孔等大等圆3mm,对光反射存在;外耳道无脓性分泌物,听力正常;鼻畅,鼻腔无脓性分泌物;咽无充血,扁桃体不大,伸舌居中。颈软,气管居中,甲状腺不大,颈静脉无怒张,肝颈反流征(-)。左侧胸廓呼吸运动减弱,触觉语颤减弱,叩诊呈鼓音,听诊左侧呼吸音减低,未闻及明显干湿啰音;心率76次/分,律齐,各瓣膜听诊区未闻及明显病理性杂音。腹平软,肝脾肋下未及,无压痛反跳痛,移动性浊音(-),肠鸣音正常。脊柱四肢生理弯曲存在,活动自如,双下肢无水肿。肛门外生殖器:未检。生理反射存在,病理反射未引出。【辅助检查】胸部CT提示:左侧气胸。

- 简答题1、该患者诊断及依据有哪些?
关注下方微信公众号,搜题查看答案

- 简答题2、需要与哪些疾病相鉴别?
关注下方微信公众号,搜题查看答案

- 简答题3、患者应采取哪些护理措施?
关注下方微信公众号,搜题查看答案

热门试题
- 1、该患者符合十二指肠溃疡的表现有哪些?
- 1、该患者什么时候可以停止输液?2、该患
- 1、为明确诊断,还需做哪些检查可以确诊?
- 1、该患者目前存在的护理问题有哪些?2、
- 1、糖尿病酮症酸中毒与糖尿病非酮症高渗状
- 1、急性心力衰竭诊断依据有哪些?2、急性
- 1、该患者诊断的依据有哪些?2、简述相关
- 1、根据以上介绍,患者最有可能发生了什么
- 1、患者的诊断及依据有哪些?2、当前患者
- 1、重症肌无力的临床表现有哪些?2、重症
- 1、该患者目前病情观察与护理的要点有哪些
- 1、该患者目前存在的护理问题有哪些?2、
- 1、患者为77岁老人,既往有左臂、右臂及
- 1、该患者目前存在的护理问题有哪些?2、
- 1、该患者可能诊断为?2、与之相关鉴别疾
- 1、患者诊断依据是什么?2、过敏性紫癜的
- 1、该患者目前存在的护理问题有哪些?2、
- 1、患者诊断依据是什么?2、从咯血症状出
- 1、该患者初步诊断为?2、还需要与哪些疾
- 1、该患者护理体检应侧重于哪些方面?为什